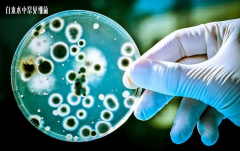
净水器不用更换滤芯?洗一洗看起来就干净了?

净水器行业发展现状如何?利润怎么样?2020年还能做吗?
在整个国际市场而言,国内净水器行业发展算是比较慢的。但是在国内家电市场而言,净水器行业作为一个后起之秀又在不断发力,来势越来越凶猛。 新生行业无可避免的一个缺点就是没有一个相关的统一标准,价格虚高,价值忽高忽低,虚假宣传一些毫无实际意义的技术等等。这些都是 净水器 行业发展受到限制的主...

在整个国际市场而言,国内净水器行业发展算是比较慢的。但是在国内家电市场而言,净水器行业作为一个后起之秀又在不断发力,来势越来越凶猛。 新生行业无可避免的一个缺点就是没有一个相关的统一标准,价格虚高,价值忽高忽低,虚假宣传一些毫无实际意义的技术等等。这些都是 净水器 行业发展受到限制的主...

随着社会的发展,更多的人想到的不是从业而是创业了。净水器作为家电行业的后起之秀得到了不少有识之士的关注和认可,越来越多的人开始做净水器代理加盟商。但是随着从业人员的增加,蛋糕也越划越小, 2020年 净水器代理加盟 商应该如何做才能从这个市场上去拿到更多利润呢? 1、用户分析 (1)对家庭用户的...

随着社会的发展,更多的人想到的不是从业而是创业了。净水器作为家电行业的后起之秀得到了不少有识之士的关注和认可,越来越多的人开始做净水器代理加盟商。但是随着从业人员的增加,蛋糕也越划越小, 2020年 净水器代理加盟 商应该如何做才能从这个市场上去拿到更多利润呢? 1、用户分析 (1)对家庭用户的...

净水器自诞生以来从不被认可到盛行,只经历了短短十余年时间。净水器虽然算是家电的一种,但是又与传统家电不太一样。就好比客户买一个电视就是为了收看节目,买一台冰箱就是为了存放食物。而买一台净水器,带来的好处和实际似乎又不是那么肉眼可见。同时,净水器的使用又需要不断的更换滤芯以及清洗等等...

现在越来越多的人开始使用 净水器 ,但是很多净水器到了冬天就开始出现各种各样的小问题了。或者是水管爆裂、或者是制水少了等等。那么我们遇到这些问题应该怎么处理呢? 冬季降温,家用涉水设备应注意防冻,那么如何处理净水器的防冻操作呢 ? 1、 温度太低,水管爆裂 由于热膨胀和冷收缩的特点,当温度变化...

净水器 自问世以来,就不断受到广大消费者的关注。不断的有人问,这个净水机有没有必要装、自己那里的水质是否用得上、装了有什么好处等等问题。那么在我们生活中,哪些人更需要净水器呢?威世顿从事净水器生产研发十余年,总结了一下,下面这五类人就是最需要的! 1.孕妇 水污染有可能会导致孕妇流产或是和...

净水器发展至今,各种原材料层出不穷,对消费者选购产生了极大打困扰,最近比较火热的是威世顿净水器的椰壳活性炭,这是一种什么材料呢?对于净化水有什么效果呢?下面我们就一起来看看。 活性炭:黑色粉末状或块状、颗粒状、蜂窝状的无定形碳,也有排列规整的晶体碳。 活性炭是一种非常优良的吸附材料,...
净水器打开了来看也没什么很特别的技术,滤芯打开了看起来也很好清洗的样子。部分老年人也非常节俭,剩饭剩菜舍不得扔掉,甚至觉得 净水器 的滤芯洗一洗也可以继续使用! 大家安装净水器就是为了用水放心一些,自来水经过净水器的净化之后,水质变干净了,但能够使自来水变干净,都是滤芯的功劳,那么过滤...

净水器行业发展至今,越来越多的商家看到了里面的 “钱景” 。在这个行业里,不断有新品牌出现,也不断有厂家倒闭,更甚于有不少 净水器代理加盟 商亏得血本无归。那么对于家庭用户而言,太多的品牌反而不好选择了。下面威世顿净水器为大家分析一下。 一、小品牌净水器 1、追求利润 找个偏僻的郊区租几间民...

近年来,时代发展速度越来越快,但是在这些年环境却呈现出反向发展。水污染的频现,净水器开始得到了广泛的关注和认可。净水器作为家电行业的一个分支,开始异军突起。有远见的商家、投资者不断的涌入这个行业。虽然时下,很多人看好这个市场,也想做 净水器代理加盟 。但是,净水器行业还是一个新兴的行...